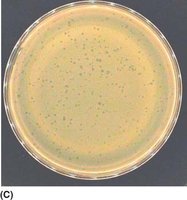
Bacteriophage plaque assay

Back
BackViruses: Structure, Classification, and Impact in Microbiology
Study Guide - Smart Notes

Introduction to Virology
Definition and Scope
Virology is the branch of microbiology that studies viruses, their structure, classification, evolution, and interactions with host organisms. Viruses are significant in medicine, ecology, and biotechnology due to their roles in disease, genetic exchange, and therapeutic applications.
Recent viral epidemics: Examples include SARS-CoV-2 (COVID-19) and Monkeypox virus.


Characteristics of Viruses
Obligate Intracellular Parasites
Viruses cannot replicate or perform metabolic processes independently. They require a living host cell to reproduce, utilizing the host's ATP, enzymes, and ribosomes.
Acellular Structure
Viruses are not made of cells. A single viral particle, or virion, consists of genetic material (DNA or RNA) enclosed in a protein shell called a capsid.

Small Size
Viruses are ultramicroscopic, typically 20–400 nm in size, much smaller than bacteria or eukaryotic cells.
Diverse Hosts
Viruses infect a wide range of organisms, including animals, plants, fungi, bacteria (bacteriophages), and archaea. Many viruses are highly specific to certain cell types or species.
Evolution and Mutation
Viruses mutate rapidly during replication, enabling adaptation and the emergence of new strains, including drug-resistant variants.
Virus Structure
Genetic Material (Genome)
The viral genome can be DNA or RNA, single- or double-stranded, linear or circular. It encodes the information necessary for viral replication.

Capsid
The capsid is a protein shell made of repeating subunits called capsomeres. It protects the viral genome and determines the virus's shape and symmetry.
Icosahedral: 20-sided, e.g., Adenovirus
Helical: Rod-shaped, e.g., Tobacco Mosaic Virus
Complex: e.g., Bacteriophages


Envelope (Optional)
Some viruses have a lipid envelope derived from the host cell membrane, containing viral glycoproteins that facilitate host cell entry. Enveloped viruses are generally less stable outside the host.

Glycoprotein Spikes (Optional)
Spikes are viral proteins embedded in the envelope, crucial for attachment to host cell receptors and entry.

Virus Architecture and Nomenclature
Virion vs. Virus
A virion is the fully assembled, infectious form of a virus outside a host cell. The term virus can refer to the virion, the virus inside a host cell, or viral genetic material integrated into host DNA.
Function of a Virion
Infection: Responsible for infecting host cells.
Replication: Disassembles inside the host to release genetic material for new virus production.

Structure and Components of a Virion
Nucleic acid: DNA or RNA, single- or double-stranded, linear or circular.
Capsid: Protein shell made of capsomeres, provides protection and stability.
Envelope (if present): Lipid membrane with embedded glycoproteins.


Capsid Symmetry Types
Icosahedral: Spherical, 20-sided (e.g., Adenovirus)
Helical: Rod-shaped (e.g., Tobacco Mosaic Virus)
Complex: Multiple components (e.g., Bacteriophage)

Early Virus Studies and Discovery
Historical Milestones
Viruses were first defined as agents that pass through filters trapping bacteria (e.g., Chamberland porcelain ultrafilters).
Tobacco mosaic virus (TMV) was the first virus discovered and visualized by electron microscopy.
Bacteriophages were isolated from sources like sewage and shown to infect bacteria.

Viruses That Challenge the Definition
Giruses and Virophages
Giruses: Giant DNA viruses (e.g., Mimivirus, Mamavirus) with large genomes and complex structures.
Virophages: Subviral agents that infect other large viruses (e.g., Sputnik virophage).


Human and Aquatic Viromes
Definition and Impact
The virome is the collection of all viruses present in a particular environment, such as the human body or aquatic ecosystems. The human virome is a component of the microbiome and can influence health and disease states.
Human virome: Includes viruses on the skin, gut, and other body sites; studied by metagenomics.
Aquatic viromes: Affect ecology, evolution, and health of aquatic organisms.
Applications of Viruses in Health and Medicine
Bacteriophage therapy: Uses viruses to target and destroy bacterial pathogens, including antibiotic-resistant strains.
Gene therapy: Employs viral vectors (e.g., retroviruses, adenoviruses) to deliver functional genes to treat genetic disorders.
Virus Nomenclature and Classification
Virus Nomenclature
Viruses are named and classified using a hierarchical system governed by the International Committee on Taxonomy of Viruses (ICTV). This system ensures consistency and clarity in scientific communication.
Taxonomic hierarchy: Order (-virales), Family (-viridae), Genus (-virus), Species
Binomial species naming: Genus name + species epithet (e.g., Orthoflavivirus zikaense for Zika virus)


Importance of Virus Nomenclature
Prevents confusion in scientific and medical communication
Facilitates epidemiological tracking and public health response
Supports regulatory approval of vaccines and diagnostics
Enables research collaboration
Baltimore Classification
The Baltimore classification system categorizes viruses based on their type of genetic material (DNA or RNA) and their mechanism of mRNA synthesis. All viruses must produce mRNA to synthesize proteins and replicate.
Seven classes:
dsDNA viruses
ssDNA viruses
dsRNA viruses
+ssRNA viruses
–ssRNA viruses
RNA reverse-transcribing viruses
DNA reverse-transcribing viruses

Summary Table: Virus Structure Components
Component | Description | Function |
|---|---|---|
Genome | DNA or RNA, single- or double-stranded | Encodes viral proteins and replication instructions |
Capsid | Protein shell made of capsomeres | Protects genome, determines shape, aids infection |
Envelope (optional) | Lipid membrane from host cell | Contains glycoproteins for host entry |
Glycoprotein spikes (optional) | Viral proteins in envelope | Attachment to host cell receptors |
Summary Table: Baltimore Classification
Group | Genome Type | Example |
|---|---|---|
I | dsDNA | Adenovirus |
II | ssDNA | Parvovirus |
III | dsRNA | Reovirus |
IV | +ssRNA | Poliovirus |
V | –ssRNA | Influenza virus |
VI | ssRNA-RT | HIV |
VII | dsDNA-RT | Hepatitis B virus |
Key Terms and Definitions
Virion: Complete, infectious virus particle outside a host cell.
Capsid: Protein shell protecting the viral genome.
Capsomere: Protein subunit of the capsid.
Envelope: Lipid membrane surrounding some viruses.
Glycoprotein spike: Protein on the viral envelope for host cell attachment.
Virome: The total collection of viruses in a specific environment.
